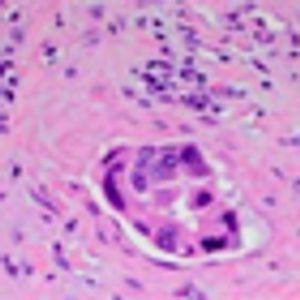
A Large Cystic Pancreatic Mass in a 45-Year-Old Female

A recent survey of the medical oncologists and oncology nursing staff at UCH showed that 71% of physicians feel Beacon has made patient treatment easier for providers.

Your AI-Trained Oncology Knowledge Connection!


A recent survey of the medical oncologists and oncology nursing staff at UCH showed that 71% of physicians feel Beacon has made patient treatment easier for providers.

A 65-year-old woman with rheumatoid arthritis and autoimmune hepatitis presented to clinic for evaluation of a liver mass. Six months prior to presentation, workup was initiated for elevated liver enzyme levels.

The patient is an otherwise healthy 45-year-old female who presented to her primary care physician with 6 weeks of increasing left upper quadrant abdominal pain with radiation to the back. She underwent an abdominal ultrasound, which revealed a large cystic abdominal mass.
Published: July 15th 2013 | Updated:

Published: November 15th 2013 | Updated:

Published: February 15th 2014 | Updated: